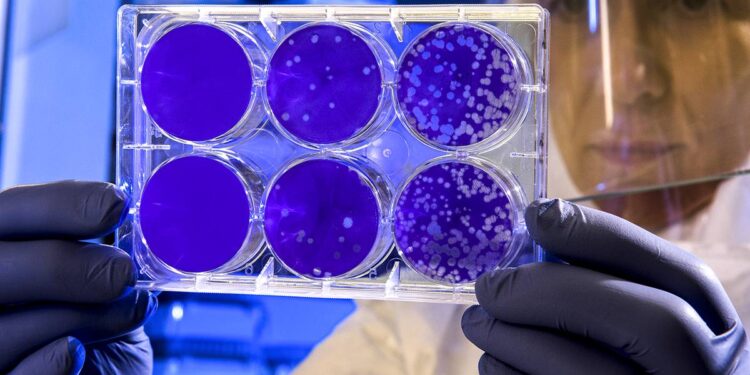
variantes de la India y Sudáfrica

Los casos fueron derivados para cumplir el aislamiento en hoteles y se informó a las jurisdicciones para que realicen el seguimiento de los contactos estrechos.
El Ministerio de Salud de Nación, a través del Instituto ANLIS MALBRAN, confirmó hoy el diagnóstico de SARS-CoV-2 con secuenciación de variantes prioritarias en tres viajeros, en dos casos se trata de las variantes B.1.617.2 y B.1.617.1 (originariamente aislada en India) y en un tercero de la variante B.1.351 (originariamente aislada en Sudáfrica).
“Desde que iniciamos la vigilancia de secuenciación genómica en viajeros, hemos identificado variantes denominadas prioritarias en casi el 50% de los casos positivos, pero, esta es la primera vez que encontramos las variantes B.1.617.2 y B.1.617.1 (originariamente aislada en India) y B.1.351 (originariamente aislada en Sudáfrica)”, indicó Analía Rearte, directora Nacional de Epidemiologia e Información Estratégica del Ministerio de Salud de la Nación.
La funcionaria explicó que “dentro del protocolo de procedimientos para los ingresos a Ezeiza desde el exterior, a todas las personas se les realiza un test de antígenos; a los que son positivos se los envía a un hotel en la Ciudad de Buenos Aires a cumplir el aislamiento, y además se envían las muestras a secuenciar al laboratorio Malbrán”.
De esa secuenciación surge que, en los dos primeros casos -en dos menores de edad procedentes de París y residentes de Ciudad de Buenos Aires-, se halló la variante B.1.617.2 y B.1.617.1 (originariamente aislada en India); mientras que en el tercero -en una persona de 58 años, procedente de España y residente de la provincia de Río Negro- se aisló la variante B.1.351 (originariamente aislada en Sudáfrica).
Los tres viajeros ingresaron al país el 24 de abril, y fueron derivados para la realización del asilamiento correspondiente a un hotel de la Ciudad de Buenos Aires. El día 26 de abril, se notificó a las jurisdicciones para que realicen las acciones de seguimiento de los contactos estrechos.
Según informaron las jurisdicciones a la autoridad sanitaria nacional, los niños cumplieron el aislamiento junto a sus padres, aunque éstos fueron negativos, y el adulto cursó el aislamiento de 10 días con síntomas leves.

Más historias
Abuelas de Plaza de Mayo anunció el hallazgo del nieto 131
El Gobierno cerró un congelamiento de precios para la indumentaria
Medicamentos subieron por encima de la inflación